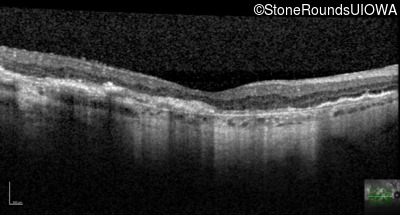
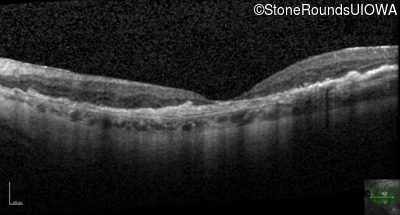
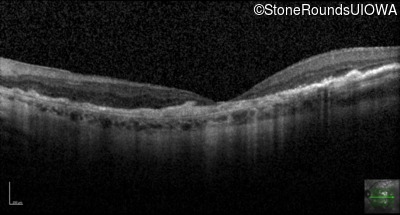
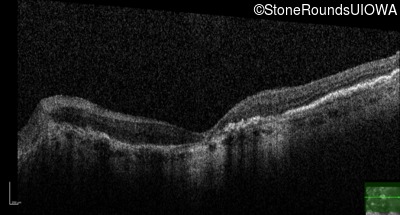
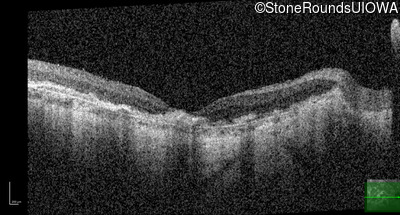

Case
SR41
Student Mode
Sorsby Fundus Dystrophy (IIH)
Female
Female
Hidden
SR41
Student Mode
Sorsby Fundus Dystrophy (IIH)
Female
Female
History
This 64 year old woman first noticed some distortion in her vision at age 46 while looking at graph paper.
| Age at visit: 64 years |
| Age at visit: 65 years |
| Age at visit: 66 years |
Diagnosis & molecular findings
| Disease | Gene | Allele 1 variant(s) | Allele 2 variant(s) | Inheritance mode |
|---|---|---|---|---|
| Sorsby Fundus Dystrophy | TIMP3 | Ser38Cys TCC>TGC | AD |